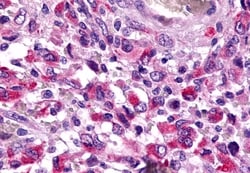
Invitrogen TAAR6 Polyclonal Antibody 50 &mu;g; Unconjugated:Antibodies

missing translation for 'onlineSavingsMsg'
Learn More
Learn More
Invitrogen™ TAAR6 Polyclonal Antibody


Rabbit Polyclonal Antibody
Marca: Invitrogen™ PA534241
Questo articolo non è restituibile.
Consulta la politica di reso
Descrizione
Percent identity with other species by BLAST analysis: Human, Chimpanzee (100%) Bovine (94%) Mouse, Hamster, Pig (88%) Monkey, Horse (81%).
Trace amines are biogenic amines present in very low levels in mammalian tissues. Although some trace amines have clearly defined roles as neurotransmitters in invertebrates, the extent to which they function as true neurotransmitters in vertebrates has remained speculative. Trace amines are likely to be involved in a variety of physiological functions that have yet to be fully understood. Expressed at low abundance in various brain tissues, as well as in fetal liver, but not in the cerebellum or placenta. In the brain, comparable levels of expression in basal ganglia, frontal cortex, substantia nigra, amygdala and hippocampus, highest expression in hippocampus and lowest expression in basal ganglia.
Specifica
| TAAR6 | |
| Polyclonal | |
| Unconjugated | |
| TAAR6 | |
| Gm228; mTaar6; RP11-295F4.3; TA4; TAAR6; TAR4; taR-4; TAR6; taR-6; trace amine associated receptor 6; trace amine receptor 4; trace amine receptor 6; trace amine-associated receptor 6; trace-amine-associated receptor 6; TRAR4 | |
| Rabbit | |
| Antigen affinity chromatography | |
| RUO | |
| 319100 | |
| Store at 4°C short term. For long term storage, store at -20°C, avoiding freeze/thaw cycles. | |
| Liquid |
| Immunohistochemistry (Paraffin) | |
| 1 mg/mL | |
| PBS with 0.1% sodium azide | |
| Q96RI8 | |
| TAAR6 | |
| Synthetic 16 amino acid peptide from 3rd cytoplasmic domain of human TAAR6. | |
| 50 μg | |
| Primary | |
| Human | |
| Antibody | |
| IgG |
Correzione del contenuto del prodotto
Fornite il vostro feedback sul contenuto del prodotto compilando il modulo sottostante.
Titolo del prodotto
Individuate un'opportunità di miglioramento?Condividi una correzione di contenuto